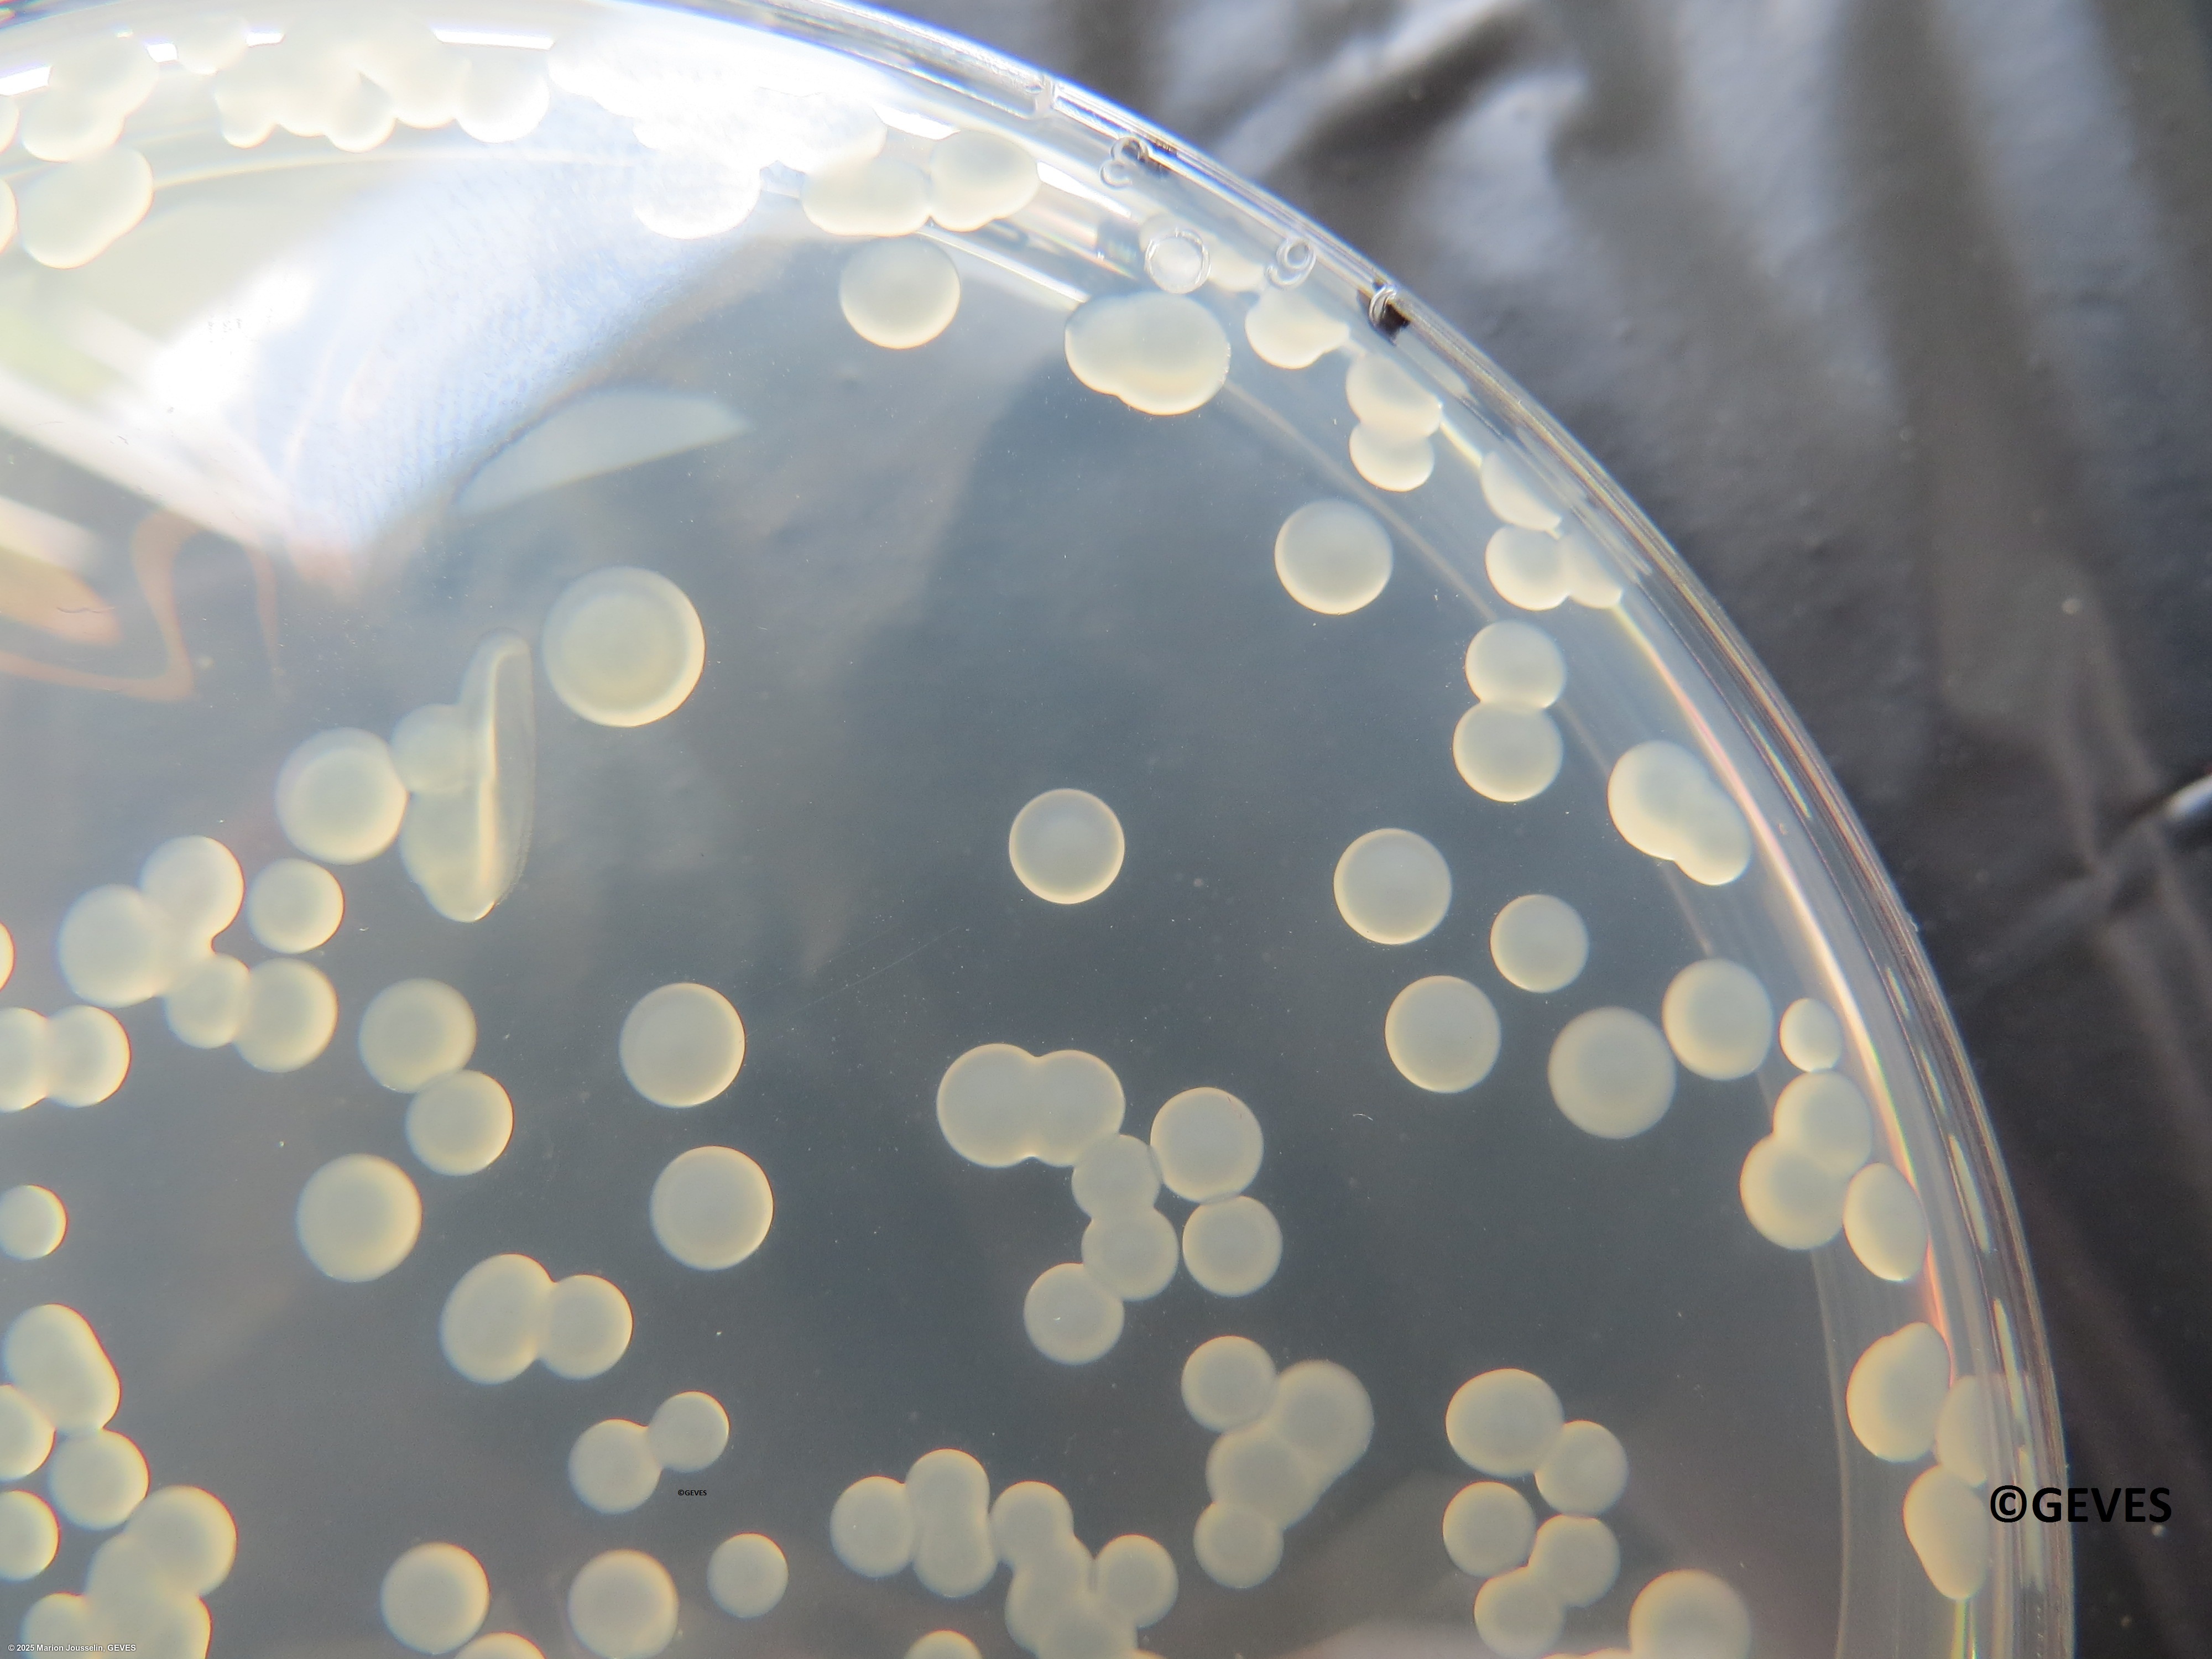

Pseudomonas syringae pv. pisi
Overview
|
Scientific name
|
Pseudomonas syringae pv. pisi |
|
Genus
|
Pseudomonas |
|
EPPO code
|
PSDMPI |
|
Common name
|
Bacterial Blight on Pea |
|
Synonyms
|
Pseudomonas pisi |
Description
From ISTA method 7-029:
On KBBCA after 4 days, Psp colonies are creamy and half-translucent.
On SNAC after 4 days, Psp colonies are circular, white to transparent, mucoid, dome shaped and levan positive.
Suspect colonies, subcultured on SNAC medium will be levan positive. Suspect colonies, subcultured on KBBCA medium, will show blue fluorescence under UV light. Using an oxidase test, Psp colonies should be oxidase negative (no cytochrome C oxidase)l no red staining.
Pathogenicity tests should be on a pea cultivar known to be susceptible to all races of Psp (e.g. Kelvedon Wonder). AFter 5-9 days, examine seedling for typical greasy lesions on stems and leaflets.